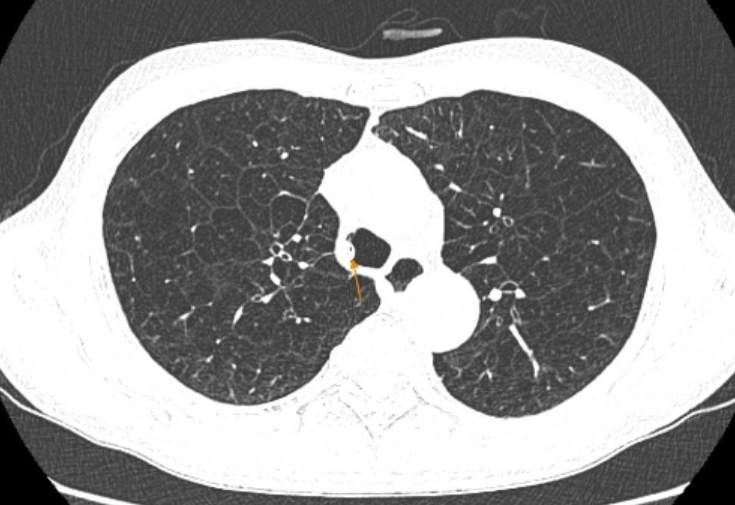

-
Đưa thuốc thế hệ mới về Việt Nam, hỗ trợ kiểm soát nguy cơ bệnh tim mạch -
Tưởng mất ngủ do tuổi tác, người phụ nữ phát hiện u màng não khi khám sức khỏe -
Kết nối VNeID, xây dựng hồ sơ sức khỏe điện tử cho toàn dân -
Tin mới y tế ngày 22/6: Bước tiến mới trong điều trị bạch biến mở ra hy vọng cho người bệnh -
Những bước chân lặng lẽ ở hành lang bệnh viện -
Bệnh viện Bạch Mai cơ sở Ninh Bình sẵn sàng đón bệnh nhân từ ngày 26/6
Bệnh viện Đa khoa MEDLATEC vừa tiếp nhận một trường hợp bệnh phổi tắc nghẽn mạn tính (COPD) ở bệnh nhân nam 66 tuổi, có tiền sử hút thuốc lá nhiều năm.
Bệnh nhân là ông L.H.Q. (66 tuổi). Theo chia sẻ, khoảng 3 tháng trở lại đây, ông thường xuyên xuất hiện các cơn khó thở, kể cả khi đi bộ trên mặt phẳng, khả năng gắng sức giảm rõ rệt. Mỗi khi khó thở, bệnh nhân phải sử dụng thuốc xịt cắt cơn và chỉ cải thiện tạm thời. Ngoài ra, ông còn có triệu chứng ho, khạc đờm trắng kéo dài nên quyết định đến bệnh viện thăm khám.
![]() |
|
COPD là bệnh lý đặc trưng bởi tình trạng tắc nghẽn đường thở không hồi phục, tiến triển tăng dần theo thời gian. |
Khai thác tiền sử cho thấy, bệnh nhân hút thuốc lá lâu năm, tương đương 40 bao.năm và hiện chưa cai thuốc. Trước đó khoảng một năm, ông từng được chẩn đoán mắc COPD nhưng chỉ sử dụng thuốc xịt khi lên cơn, chưa dùng thuốc dự phòng đợt cấp. Trong vòng một năm qua, bệnh nhân chưa phải nhập viện vì khó thở.
Qua thăm khám lâm sàng, các chỉ số sinh tồn của bệnh nhân ổn định, SpO₂ đạt 98% khi thở khí trời, huyết áp 120/80 mmHg. Lồng ngực cân đối, hình thùng là đặc điểm thường gặp ở bệnh nhân COPD lâu năm. Phổi giảm thông khí hai bên, không ghi nhận ran rít hay ran ngáy.
Đánh giá mức độ khó thở theo thang điểm mMRC, bệnh nhân đạt 2 điểm, tương ứng với tình trạng đi bộ chậm hơn so với người cùng tuổi do khó thở.
Kết quả đo chức năng hô hấp cho thấy nhiều chỉ số suy giảm rõ rệt. FVC đạt 3,0 lít, tương đương 76% giá trị dự đoán (bình thường ≥ 80%), gợi ý rối loạn thông khí hạn chế. FEV1 đạt 1,36 lít, tương đương 44% (bình thường ≥ 80%), cho thấy mức độ tắc nghẽn đường thở nặng. Tỷ lệ FEV1/FVC là 0,45 (bình thường ≥ 0,7), khẳng định rối loạn thông khí tắc nghẽn.
Dựa trên các chỉ số này, bác sỹ kết luận bệnh nhân có rối loạn thông khí tắc nghẽn mức độ nặng, kèm theo rối loạn thông khí hạn chế mức độ nhẹ.
Kết quả chụp CT phổi ghi nhận hình ảnh viêm phế quản mạn tính, giãn phế nang lan tỏa hai phổi là những tổn thương điển hình của COPD, kèm ứ đọng dịch nhầy trong lòng khí quản.
Từ các dấu hiệu lâm sàng và cận lâm sàng, bệnh nhân được chẩn đoán xác định mắc bệnh phổi tắc nghẽn mạn tính (COPD) nhóm B.
Theo Ths.Mai Thị Ngân, chuyên khoa Hô hấp, Bệnh viện Đa khoa MEDLATEC, phân loại COPD theo hướng dẫn GOLD 2025 chia bệnh thành ba nhóm A-B-E. Trong đó, nhóm B là những bệnh nhân có triệu chứng khó thở rõ (mMRC ≥ 2), không có hoặc chỉ có một đợt cấp trong năm và chưa phải nhập viện trong vòng một năm qua. Các tiêu chí này hoàn toàn phù hợp với trường hợp của bệnh nhân L.H.Q.
Sau khi được chẩn đoán, bệnh nhân được kê đơn điều trị ngoại trú, tư vấn thay đổi lối sống và hẹn tái khám định kỳ. Theo Ths.Mai Thị Ngân, COPD là bệnh mạn tính không thể chữa khỏi hoàn toàn nhưng có thể kiểm soát hiệu quả nếu phát hiện sớm và điều trị đúng. Trong đó, cai thuốc lá là biện pháp quan trọng nhất, giúp làm chậm tiến triển bệnh và cải thiện chất lượng cuộc sống cho người bệnh.
Các bác sỹ cho biết, COPD là bệnh lý đặc trưng bởi tình trạng tắc nghẽn đường thở không hồi phục, tiến triển tăng dần theo thời gian.
Nguyên nhân thường gặp gồm hút thuốc lá (chủ động hoặc thụ động), viêm phế quản mạn tính kéo dài và khí phế thủng gây giãn phế nang, mất đàn hồi phổi. Triệu chứng điển hình là khó thở và ho mạn tính, đặc biệt khi gắng sức. Tiêu chí chẩn đoán quan trọng là tỷ lệ FEV1/FVC dưới 0,7 sau test hồi phục phế quản.
Bác sỹ cũng lưu ý sự khác biệt giữa COPD và hen phế quản. Trong khi hen phế quản là tình trạng viêm và co thắt đường thở có khả năng hồi phục, COPD gây chít hẹp đường thở không hồi phục. Corticoid dạng hít đóng vai trò chính trong kiểm soát hen, nhưng trong COPD, thuốc giãn phế quản tác dụng kéo dài như LAMA và LABA mới là nền tảng điều trị duy trì.
Sau khi chẩn đoán COPD, người bệnh cần tuân thủ điều trị, cai thuốc lá hoàn toàn, tiêm phòng cúm, phế cầu, RSV, ho gà; đồng thời tầm soát các bệnh lý đi kèm. Bên cạnh đó, cần tránh khói thuốc, khói bụi, môi trường ô nhiễm và gió lạnh; hạn chế uống nước lạnh; tập thở cơ hoành, duy trì vận động thể lực phù hợp và tái khám đúng hẹn hoặc khi xuất hiện triệu chứng bất thường.
-
Đưa thuốc thế hệ mới về Việt Nam, hỗ trợ kiểm soát nguy cơ bệnh tim mạch -
Tưởng mất ngủ do tuổi tác, người phụ nữ phát hiện u màng não khi khám sức khỏe -
Kết nối VNeID, xây dựng hồ sơ sức khỏe điện tử cho toàn dân -
Tin mới y tế ngày 22/6: Bước tiến mới trong điều trị bạch biến mở ra hy vọng cho người bệnh
-
Những bước chân lặng lẽ ở hành lang bệnh viện -
Bệnh viện Bạch Mai cơ sở Ninh Bình sẵn sàng đón bệnh nhân từ ngày 26/6 -
Não mô cầu gia tăng, chuyên gia cảnh báo nguy cơ "dịch chồng dịch" -
Hơn 3.000 Yogi tham gia Ngày Quốc tế Yoga năm 2026 tại Quảng Ninh -
Tin mới ngày 21/6: Bộ Y tế yêu cầu bảo đảm nguồn cung, không để thiếu thuốc điều trị trong mùa hè -
Từ hành trình 7 năm tìm con đến hy vọng mới cho các gia đình hiếm muộn -
Bệnh dại gia tăng ở miền Nam, nhiều người tử vong vì tin cách chữa phản khoa học
-
Groupe PierreVal: Hành trình 3 thập kỷ từ Pháp đến Nam Sài Gòn -
Đòn bẩy chiến lược tối ưu hóa hiệu suất cho các doanh nghiệp hạ tầng trạm sạc -
Lancaster Lincoln đón sóng quy hoạch Công viên Bến Nhà Rồng - Khánh Hội -
Nutifood và Bệnh viện Quân y 175 hợp tác phát triển các giải pháp dinh dưỡng khoa học -
SeABank triển khai Ocean Cleanup 2026, hơn 1.000 cán bộ nhân viên chung tay làm sạch bờ biển -
Tây Ninh cần cụ thể hóa phạm vi thử nghiệm và cơ chế sandbox đối với UAV